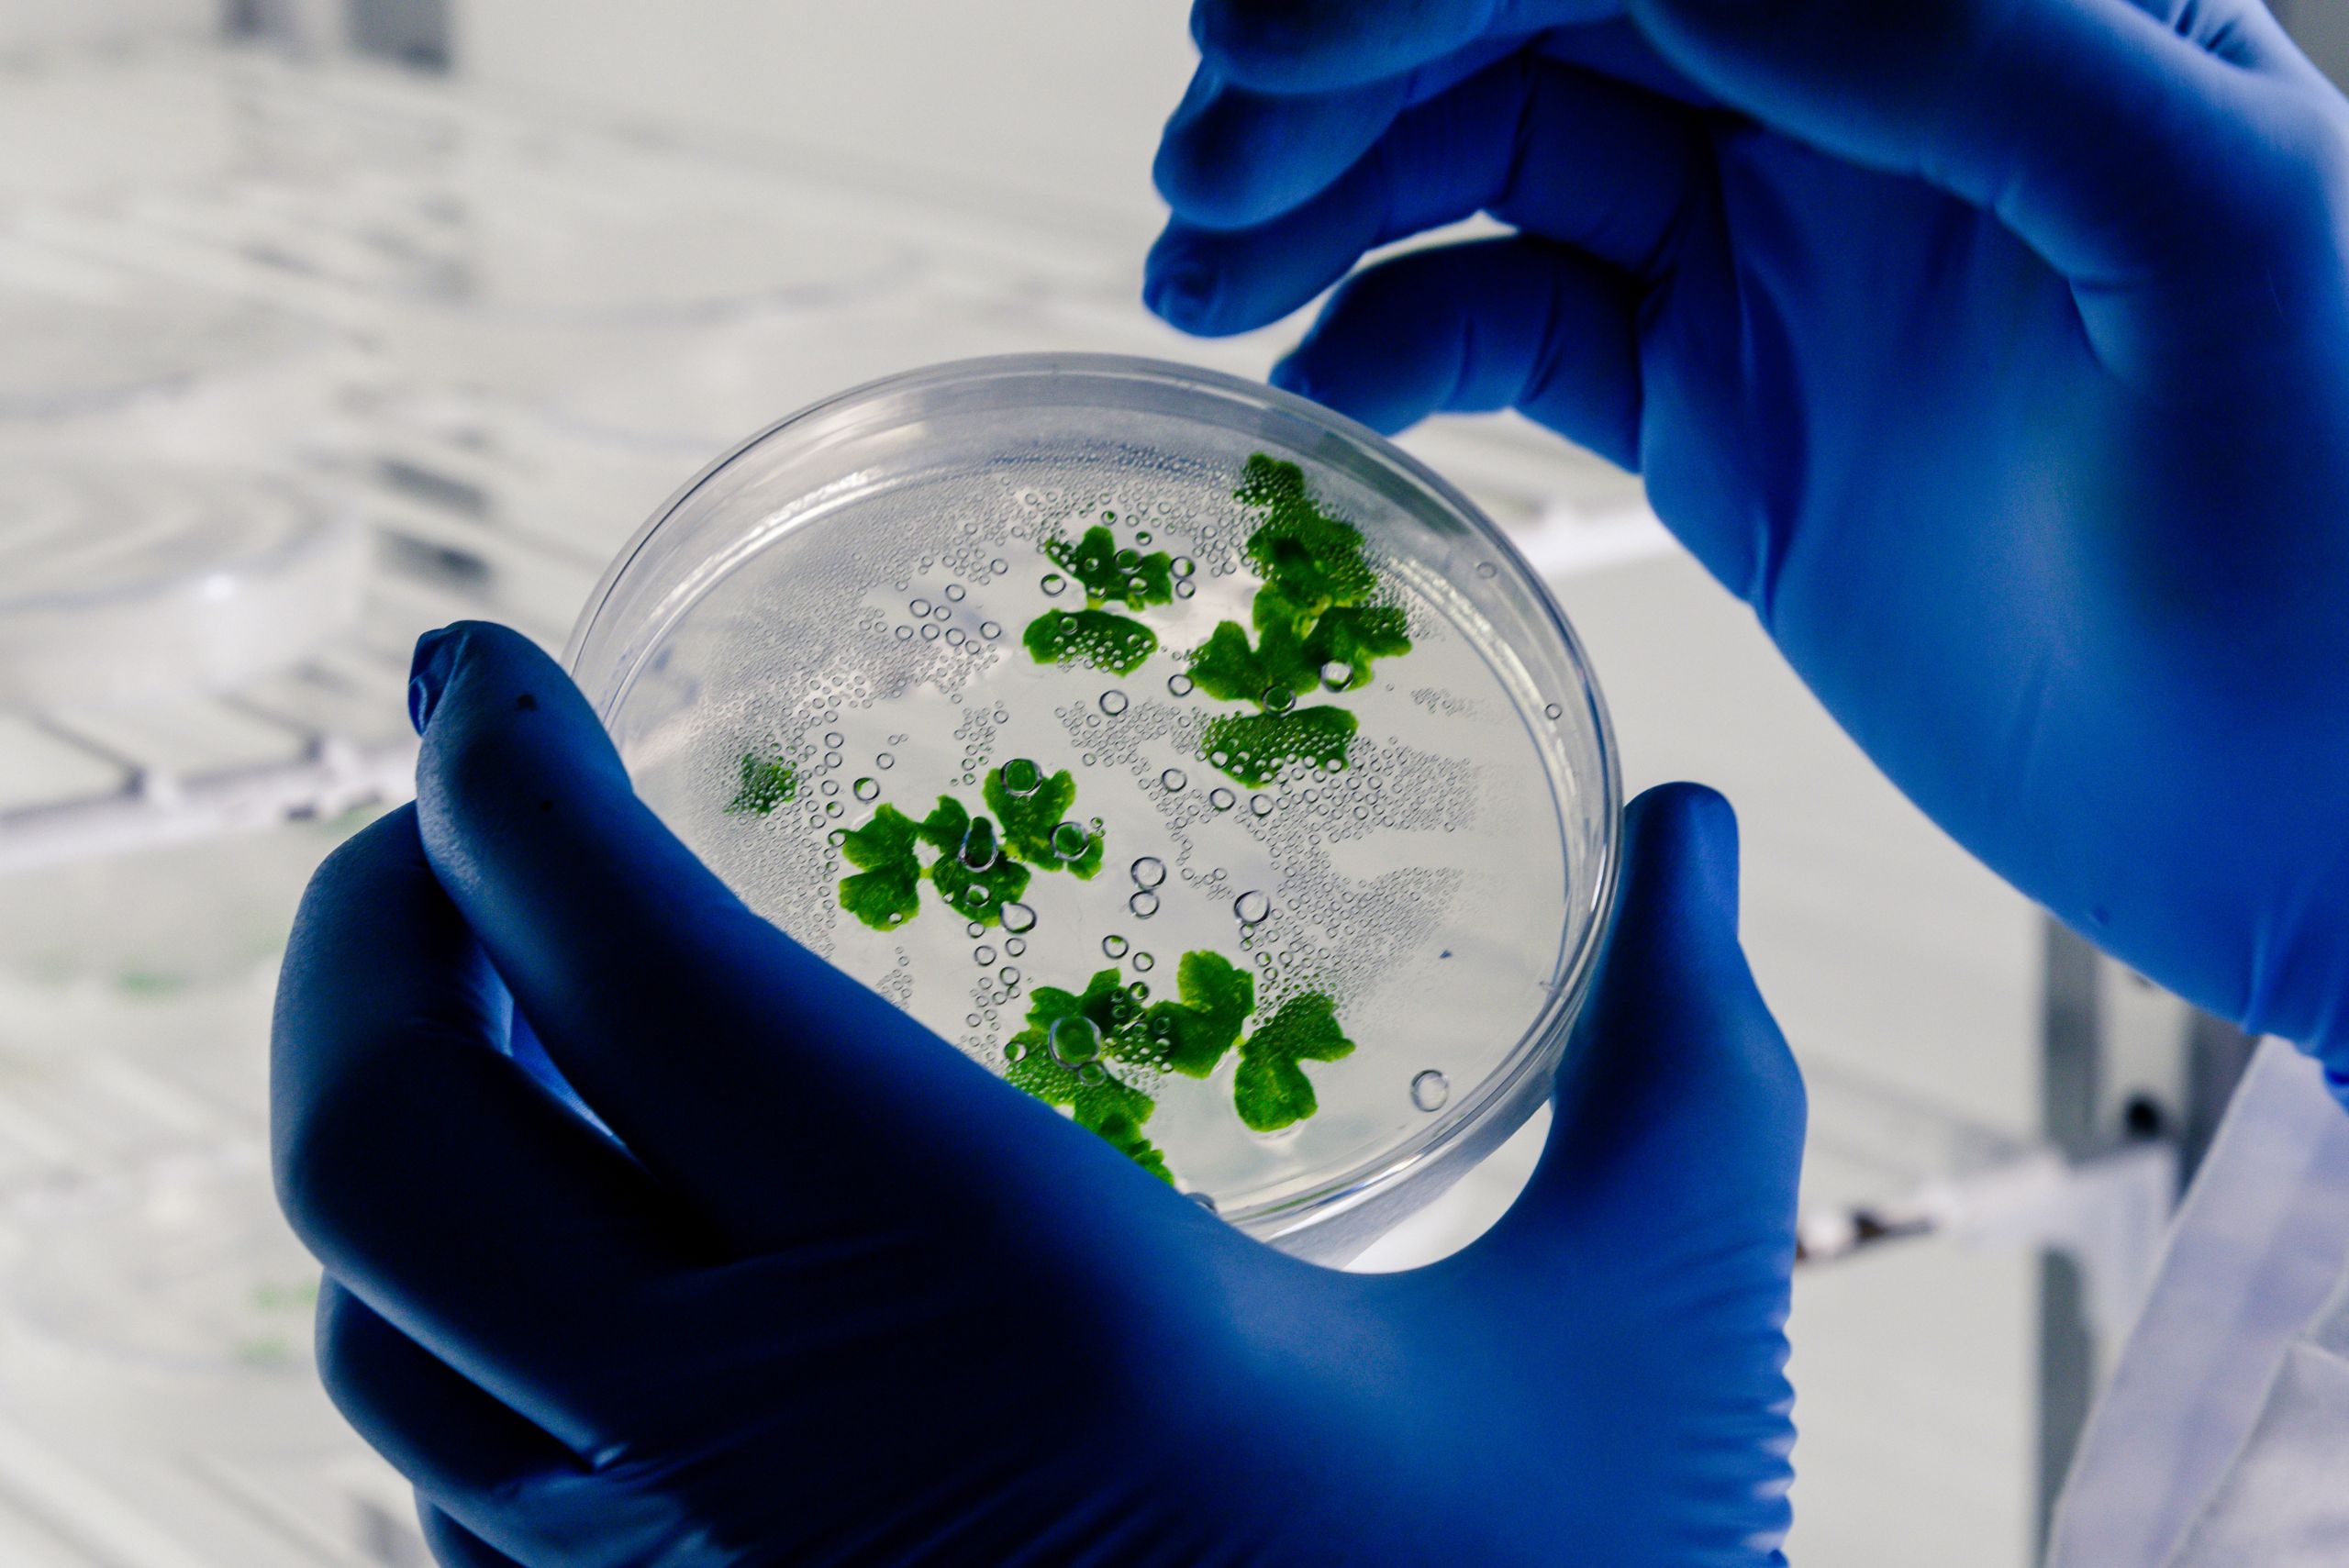

Incorporate H&H’s forefront services and solutions, built on steadfast commitment, open procedures, and constant adherence to global regulations, to cultivate trust and facilitate your brand’s smooth market debut. Learn our 3Cs to help your brand stand out from the competition.
Our proficient team tirelessly works to guarantee adherence to regulatory compliance, turning complexities into a smooth market access for you.
We keep stakeholders informed, build confidence, and cater to changing regulatory environments through proactive communication & open protocols.
From raw material to finished goods, we focus on embedding quality systems that ensure uniform complaint and QA-focused work.













Our compliance goes beyond certifications, embedding rigorous quality systems, proactive risk management, and transparent processes that align with global regulations, safeguarding product integrity from sourcing to delivery.
Beyond certificates, we ensure product integrity from sourcing to delivery by implementing strict quality systems, proactive risk management, and transparent procedures that comply with international standards.
To ensure unparalleled priority, potency, and safety to global markets, our advanced labs utilise technologies to carefully examine each ingredient and product stage.

Superior analytical methods verify the purity and molecular composition of products to make sure they fulfill strict quality standards.
Superior analytical methods verify the purity and molecular composition of products to make sure they fulfill strict quality standards.

Aligning strict stability tests with global norms confirms the product integrity across varied climatic conditions.

Protecting consumer health & regulatory compliance by implementing advanced detection & control of elemental, genotoxic, and nitrosamine impurities
H&H believes in investing in advanced training programs that foster tech proficiency & personal growth, promoting continuous improvement & a collaborative culture.
To promote strong expertise, departmental heads utilise detailed competency mapping to find out skill gaps and training needs.
Frequent training ensures that workers stay compliant with international industry standards & changing regulatory requirements.
Focused workshops foster attitude, communication, and interpersonal skills to strengthen employees’ confidence and professional growth.
In force, fascinating learning experiences and knowledge sharing are facilitated by an on-site auditorium that can accommodate 100 employees.
Quality control is more than a checkpoint, it’s an ecosystem of science, precision, and vigilance, and cannot be negotiated. H&H’s QC laboratories promise to guarantee that each material, intermediate, and finished good will meet the strictest standards for safety, purity, and efficacy by leveraging the advanced equipment & uncompromising expertise.
ICH-compliant testing across multiple climatic zones to guarantee global shelf-life stability.
Detection and control of elemental, genotoxic, and nitrosamine toxins to safeguard patient health.
Partner with excellence. Launch your branded supplements today.
India’s trusted CDMO Partner, delivering science-driven solutions across healthcare & cosmetics sectors.
© 2026 H&H Healthcare and Cosmetics Pvt. Ltd. Designed by ROI Makers.